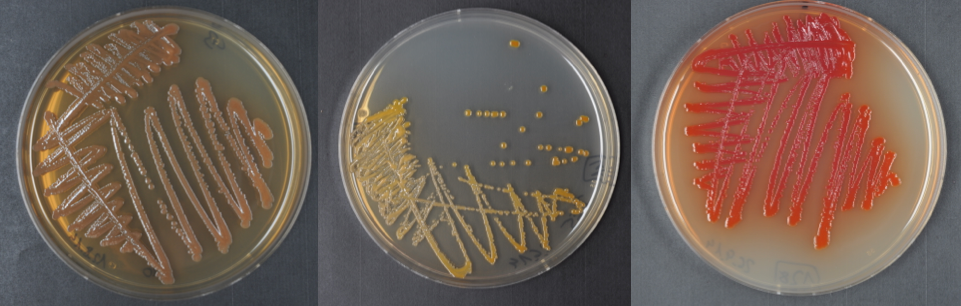

Natural products in nature: who does what and why?
Published in Microbiology
The paper in Nature Microbiology is here: http://go.nature.com/2hJsLjk
Speculation on the function of natural products in Xenorhabdus and Photorhabdus, nematode symbionts and insect killers, was ongoing well before I joined the Bode lab in 2014. With a background in bacterial genomics I felt I had something to add (and a lot to learn about the chemistries). The question playing on my mind from the start was: why do these bacteria (that I’d never really heard of) need to produce so many different natural products with such a variety of bioactivities?
As a recent arrival to Germany, I was accepting any and all opportunities to sample the local brew. One such meeting was with Hendrik, a PhD student from the Bode lab who was making some progress with high-throughput metabolomics methods. After a few drinks we (perhaps naively) agreed to try and combine my genomic and his metabolomic data into one big analysis in a bid to essentially summarize the natural products from these genera. Would we be able to identify compounds important for their given ecologies?
Initially, the metabolomic results were difficult to make sense of. Fortunately, at the time the Dorrestein lab had just developed an easy to use molecular networking tool, the GNPS, enabling us to look at the relationships between metabolites produced. In this way, we could quickly group the masses observed by mass spectrometry into families based on their fragmentation patterns and subsequently assign networks to “known” compounds.
From the genomic side of things, the first step was to look at the evolution. Is there something meaningful in the genetic data indicating that natural products are important? Encouragingly there was a clear enrichment of predicted natural product related coding sequences. Step two was whether this can be attributed to a particular clade, giving us an idea about specific ecologies across different species. This was significantly more ambiguous. After much discussion, we decided to keep it ‘simple’ and focused on secondary metabolite gene clusters. Despite very little in terms of clade specificity (and perhaps as a consequence of spending so much time digging through the raw data), we recognized that some predicted coding sequences were sometimes present in bacteria that also produced a given (unknown) metabolite family. This led us to the realization that many of the unknown gene clusters were only present in strains that also had unknown metabolite families providing several relatively straight-forward hypotheses to test.
After confirming several of the unknown cluster-compound pairs, we now realize that (as always?) the reason these bacteria produce natural products is not so simple. In fact, the inherent complexity of the lifecycle makes it very difficult to assign a definitive function to any given compound. Our original aim to determine the function of natural products in the native environment still eludes us. However, as a side effect and armed with genome sequences, we stumbled upon a faster way to assign gene clusters to compounds in a reliable way allowing us to ramp up our discovery efforts in these interesting genera of secondary metabolite producers.
Please sign in or register for FREE
If you are a registered user on Research Communities by Springer Nature, please sign in